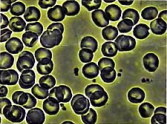

■オリンパス製 / ニコン製 顕微鏡と
比較・検討されているみなさまへ
|

写真はP-Scope |
ぜひ、P-Scope(ピースコープ)を比べてください
可能であれば、オリンパス製 / ニコン製 顕微鏡のとなりに並べて比較してください
|
○画像を比較してください
明るさ、コントラスト、解像度などとことん比較してください
○操作性を比較してください
1分でわかります
○拡張性を比較してください
オプションが豊富です
○実績を比較してください
|

写真はオリンパス「ペリオマイクロ40」
(オリンパスホームページより)
|
■「LED光源では照度が足りないのでは?」とお考えのみなさん
一昔前なら「顕微鏡、とくに位相差顕微鏡の場合、光源の明るさは重要で明るいほうが良い。40Wよりも60W、さらに100Wハロゲンランプが必ず良い」と言われていました。
光源の一部しか利用できない構造の位相差顕微鏡では、正しい考え方です
ただしそれは『目で見る』ことを前提としています
CCDカメラで映像を写すのであれば、そこまで明るい光源は必要ありません
また、最新のLEDは、数年前のものに比べて桁違いに明るいのです
<時代の進歩>
肉眼では見えない、わずか0.1Lux対応のCCDカメラと超高輝度LEDが不可能を可能にしました
|
 |
| 【画質比較】 |
 |
| 位相差顕微鏡「P-Scope」 |
一般的な位相差顕微鏡 |
 |
|
 |
 |
 |
P-Scopeは国産大口径レンズを採用しているため画面が明るく、
極少細菌まで鮮明に見えるのが特徴です。 |
|
 |
|
 |
| 【メンテナンス性比較】 |
 |
|
P-Scope(高光度LED) |
一般の顕微鏡(ハロゲンランプ) |
| 寿命 |
5万〜10万時間
通常、交換の必要は無い |
1000〜5000時間
6ヶ月〜2年程度で交換 |
| 交換コスト |
セロ(交換不要) |
数千円〜1万円 |
| 発熱量 |
発熱は微々たるもので、
直接手で触れても大丈夫 |
フィラメント部は1,000℃を越す
ガラス表面温度も100℃以上 |
| 消費電力 |
1W程度 |
50〜100W |
| 発行色 |
白色 |
やや黄色がかった発色
(古い車のヘッドライトの色) |
 |
P-Scopeは、光源に高輝度LEDを採用しています。
一般に使用されているハロゲンランプに比べて非常に長寿命です。
通常、交換の必要はありません。 |
|
 |
|
 |
| 【操作性比較】 |
 |
高倍率顕微鏡の場合、対物レンズと対象物の間に特殊な油をたらして(油浸)観察するのが一般的です。(空気よりも高い屈折率の媒体を介して結像するレンズを使用している)
P-Scopeは最大総合倍率 11,000倍(29インチモニター時)を誇りながら、
乾式レンズを採用しています。油浸の必要はありません。
明るさ調整機能は、メカニカルな絞り機構が一般的ですが、
P-Scopeはデジタル技術によりフルオートで明るさ調整。
また、スイッチの切り替えでマニュアルでの明るさ調整機能も装備
同じくデジタル技術により、今までは無理だった色合いの調整も可能になりました。 |
 |
|
 |
| 【拡張性比較】 |
 |
P-Scopeは、パソコンとの親和性も高いのが特徴です。
オプションのキャプチャーケーブルも安価で(Windows用)、ご自分のパソコンを利用して画像管理も簡単に行えます。
他社の顕微鏡では、パソコンとは接続できない場合や、専用の高価な設備を必要とする場合があります。 |
|
|
 |
|
 |
| 【機動性比較】 |
 |
P-Scopeは、軽量アルミモノコック構造採用で高い剛性と強靭な耐久性を誇ります
片手で持ち上げられる軽量ボディー
付属の梱包ケースを利用して宅配便による輸送も可能です
オプションの6インチ液晶モニターを使用すれば
外出先でも鮮明画像をご覧いただけます
一般的に、他社の顕微鏡は宅配便による輸送は
想定されていない場合が多く、また、
外出先での観察ではテレビモニターの確保を考慮する必要があります |
 |
 |
| 超軽量7インチ液晶モニター |
本体上部に取付け可能
正面・背面フリーレイアウト |
 |
 |
 |
| 軽量4.0kg |
付属梱包ケース(宅配便OK) |
 |
|
|
 |

オリンパス「ペリオマイクロ40」とP-Scope PRO(ピースコープ・プロ)のサイズ比較

P-Scope PROは小型軽量
設置サイズは130×160mm
重量は4kgで、女性でも軽々移動可能です
|
|


